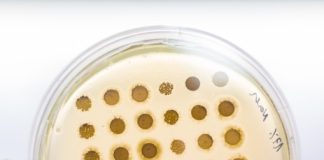
Glivične okužbe z dermatofiti

Spletni portal REVIJE ZA MOJE ZDRAVJE – www.revijazamojezdravje.si - spremlja najaktualnejše dogodke v zdravju. Uredništvo dnevno vsak dan v tednu pripravlja lastne avtorske članke in poobjavlja izbrane vsebine iz tiskane izdaje Revije za moje zdravje. Smo vzgojno izobraževalno naravnani, stremimo k odličnem razmerju med strokovnim in poljudnim jezikom. Smo spletna stran z referenčnimi informacijami in najnovejšimi izsledki prelomnih kliničnih raziskav v medicini in farmaciji.
Uredniška politika zagotavlja kakovost in kontinuiteto, vsem, ki stran obiskujete, pa želimo omogočati stik s kakovostnimi vsebinami o širokem področju zdravja in zdravega življenja.
Vabimo Vas, da se nam pridružite!
Uredniška politika zagotavlja kakovost in kontinuiteto, vsem, ki stran obiskujete, pa želimo omogočati stik s kakovostnimi vsebinami o širokem področju zdravja in zdravega življenja.
Vabimo Vas, da se nam pridružite!
Kontakt: [email protected]
© 2019 Revija za Moje zdravje | Vse pravice pridržane